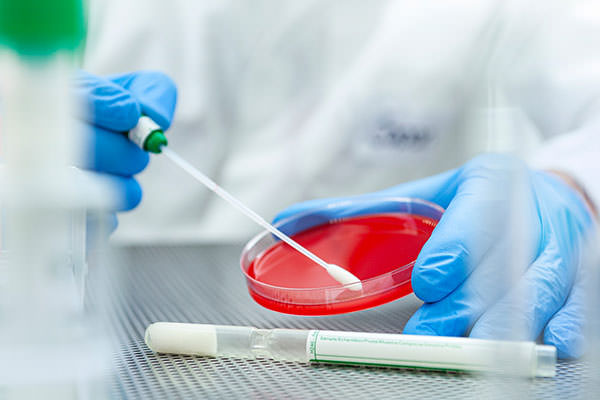

SRK®
Our Swab Rinse Kits line includes comprehensive tailor-made collection and devices for the detection of
environmental microbial contamination in a broad range of environments, such as food production, pharmaceutical sites,
and hospital wards. Inspectors and Quality Assurance personnel can use SRK® products for
routine surface monitoring within manufacturing areas, hospital surfaces, and equipment.